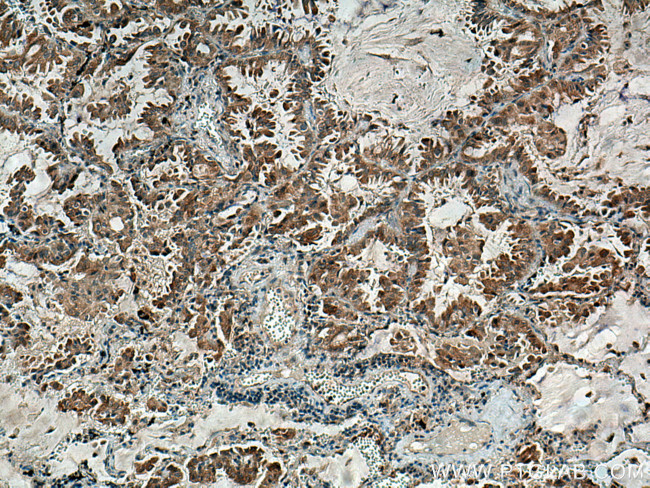
RNF145 Antibody in Immunohistochemistry (Paraffin) (IHC (P))

Search
Proteintech
RNF145 Polyclonal Antibody
{{$productOrderCtrl.translations['antibody.pdp.commerceCard.promotion.promotions']}}
{{$productOrderCtrl.translations['antibody.pdp.commerceCard.promotion.viewpromo']}}
{{$productOrderCtrl.translations['antibody.pdp.commerceCard.promotion.promocode']}}: {{promo.promoCode}} {{promo.promoTitle}} {{promo.promoDescription}}. {{$productOrderCtrl.translations['antibody.pdp.commerceCard.promotion.learnmore']}}
产品信息
24524-1-AP
种属反应
宿主/亚型
分类
类型
抗原
偶联物
形式
浓度
规格
纯化类型
保存液
内含物
保存条件
运输条件
产品详细信息
Aliquoting is unnecessary for -20°C storage.
靶标信息
E3 ubiquitin ligase that catalyzes the direct transfer of ubiquitin from E2 ubiquitin-conjugating enzyme to a specific substrate. In response to bacterial infection, negatively regulates the phagocyte oxidative burst by controlling the turnover of the NADPH oxidase complex subunits. Promotes monoubiquitination of CYBA and 'Lys-48'-linked polyubiquitination and degradation of CYBB NADPH oxidase catalytic subunits, both essential for the generation of antimicrobial reactive oxygen species. Involved in the maintenance of cholesterol homeostasis. In response to high sterol concentrations ubiquitinates HMGCR, a rate-limiting enzyme in cholesterol biosynthesis, and targets it for degradation. The interaction with INSIG1 is required for this function. In addition, triggers ubiquitination of SCAP, likely inhibiting its transport to the Golgi apparatus and the subsequent processing/maturation of SREBPF2, ultimately downregulating cholesterol biosynthesis.
仅用于科研。不用于诊断过程。未经明确授权不得转售。
生物信息学
蛋白别名: RING finger protein 145; unnamed protein product
基因别名: RNF145
UniProt ID: (Human) Q96MT1
Entrez Gene ID: (Human) 153830